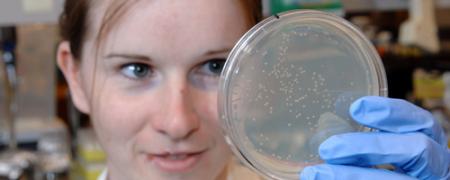
CPBP06.jpg

Program Overview
Quantitative and Chemical Biology is a transinstitutional first-year graduate program designed for students who wish to pursue a doctoral degree with a research focus at the interfaces between physical, chemical, and biological sciences. Students entering QCB typically have earned undergraduate degrees in chemistry, physics, computer science, engineering, or mathematics. Previous coursework in biology and biomedical science is not required for entry into the QCB program, although QCB also admits students with undergraduate degrees in biological sciences who wish to develop their quantitative skills. A unique aspect of the QCB Program is that students have the flexibility to explore their research interests from the offerings of the thirteen participating departments and programs prior to choosing a laboratory for their dissertation research.
More specifics on the first year QCB curriculum can be found here.
While students in the first year QCB curriculum can pursue any interests in the biomedical sciences, the coursework generally follows one of four areas of interest:
Chemical Biology

Research Focus:
The chemical biology curriculum provides advanced training and research at the chemistry biology interface using chemical approaches to understand biological systems. Research opportunities are available in abroad range of areas including:
Biological Mass Spectroscopy
Biomagnetics and Nonlinear Dynamics
Computational Biology and Molecular Modeling
Protein-protein Interactions
NMR and EPR
Drug Discovery
Chemical Biology
Protein-Nucleic Acid Interactions
Fluorescence Spectroscopy and Microscopy Structural Biology
Nanocrystals
Macromolecular Structure and Dynamics
Mechanistic Enzymology
Proteomics
Molecular Toxicology
Mathematical Modeling of Biological Systems
Structural Biology
Examples of Coursework
Biological Mass Spectroscopy
Biomagnetics and Nonlinear Dynamics
Computational Biology and Molecular Modeling
Protein-protein Interactions
NMR and EPR
Drug Discovery
Chemical Biology
Protein-Nucleic Acid Interactions
Fluorescence Spectroscopy and Microscopy Structural Biology
Nanocrystals
Macromolecular Structure and Dynamics
Mechanistic Enzymology
Proteomics
Molecular Toxicology
Mathematical Modeling of Biological Systems
Structural Biology
Structural Biology & Molecular Biology
Research Focus:
The curriculum prepares students for research careers in structural biology, molecular biophysics, or computational biology. Research opportunities are available in a broad range of areas including:
Alzheimer’s disease and protein folding disorders
Genome maintenance and cancer
Mechanistic enzymology
Membrane protein structure and function
Molecular toxicology
Viral and bacterial pathogenesis
Computational biology and structure-based design
Cryo-electron microscopy
EPR Spectroscopy
Fluorescence
NMR spectroscopy and solution scattering
Super-resolution microscopy
X-ray crystallography
Example of Coursework:
Advanced Membrane Protein Biology: From Molecule to Disease
Basic Biological Microscopy
Biochemistry: Basis of Biological Processes
Biomolecular NMR Spectroscopy
Biomolecular Physics
Biomolecular X-Ray Crystallography
Computational Structural Biochemistry
DNA Structure and Topology
Drug Design and Development
Graduate Seminar in Molecular Biophysics
Introduction to Structural Biology
Introduction to Modern Biological Microscopy
Medical Chemistry
Molecular Modeling Methods
Molecular Structure and Function
Protein-Protein Interactions Make Cells Go Round
Quantum Chemistry
Receptor Theory and Enzyme Kinetics
Spectroscopy
Systems Biology
Research Focus
Systems Biology students receive training not only in a specific biological research field, but also in the acquisition and integration of different types of quantitative data from different platforms (genomics, gene expression, proteomics, molecular, cellular, and functional data). Since these multiscale data are extremely complex, quantitative mathematical and computational modeling is required for analysis and prediction. This approach is distinct from traditional biomedical research, although it has many aspects in common with approaches that form the core of the program (biophysics, structural biology, chemical biology, and imaging science). Students in Systems Biology will take a flexible curriculum that permits in-depth coursework in both a specific disease model and state-of-the-art quantitative approaches, including mathematical modeling.
Examples of Coursework:
Molecular Structure and Function
Quantum Chemistry
Medicinal Chemistry
Physics of Medical Imaging
Molecular Modeling Methods
Computational Structural Biochemistry
Biological Basis of Imaging
Quantitative and Functional Imaging
Mathematical Methods in Imaging sciences
Foundations in Bioinformatics Neuroimaging
Systems Biology
Cancer Systems Biology
Physical Measurements of Biological Systems
Theoretical and Experimental Systems Biology
Biophysical Models of Cancer
Molecular Endocrinology
Advanced Concepts in Cancer Biology
Cell Biology
Cellular and Molecular Neuroscience
Molecular and Cellular Immunology
Imaging Sciences

Research Focus:
The imaging science curriculum provides advanced training in the physical, chemical, engineering, mathematical, medical, and biological aspects of modern in vivo imaging and spectroscopy. Students have access to an extensive didactic curriculum that includes core courses on the fundamental aspects of imaging science, courses in specialized areas of imaging sciences, and the biomedical sciences. Students may also select from a wide variety of research project opportunities, ranging from the fundamental physical aspects of image formation and contrast generation through to applications of imaging methods in clinical populations. Example research areas include:
Imaging Systems Hardware
MRI Pulse Sequence Development
Image Reconstruction
Functional and Structural Neuroimaging
In Vivo Spectroscopy
Imaging and Spectroscopy with Hyperpolarized Species
Physiological and Metabolic Imaging
Image-based Modeling
Musculoskeletal Imaging
Computational Imaging
Ultrasound: Imaging and Therapy
Contrast Mechanisms in MRI
Nuclear Imaging Methods and Applications
Statistical Image Analysis
Cellular and Molecular Imaging
Cancer Imaging
Optical Imaging
Imaging Biomarkers
Examples of Coursework
Foundations of Medical Imaging
Physics of Medical Imaging
Biological Basis of Imaging
Quantitative and Functional Imaging
Cellular and Molecular Imaging
Current Topics in Imaging Science
Image Processing
Advanced Image Processing
Neuroimaging
Mathematical Methods in Imaging Science
Cancer Imaging
Mathematical Methods for Physicists
Quantitative Methods in Biomedical Engineering
Molecular Probe Development
Magnetic Resonance Imaging